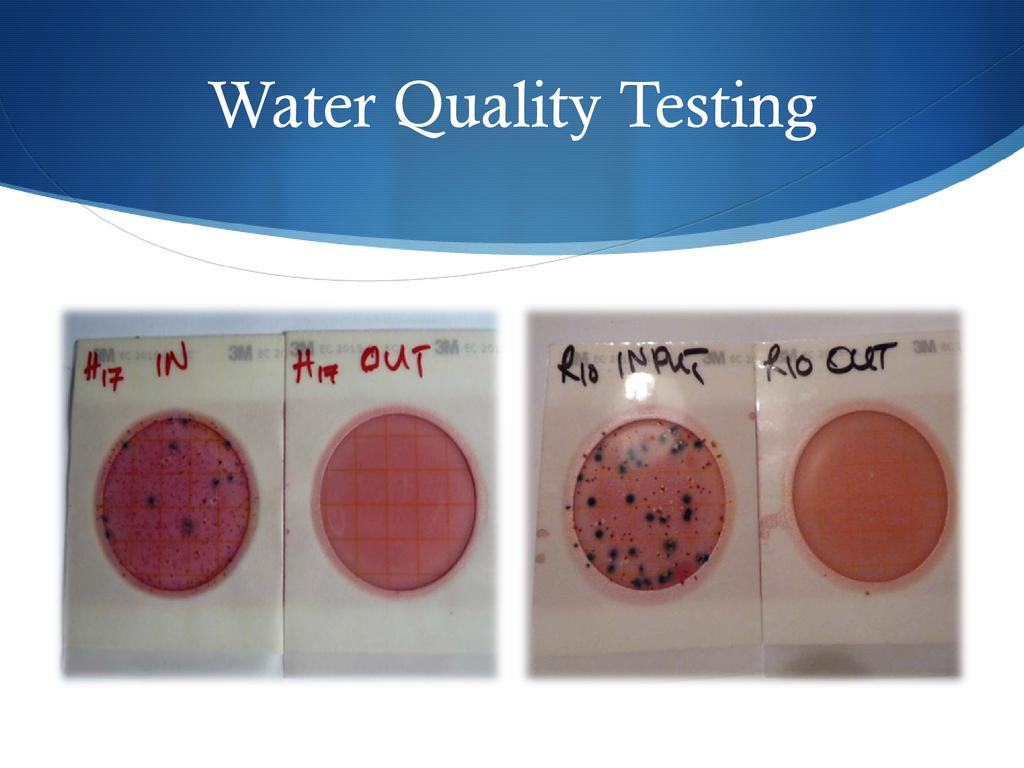

Presented By: JOHN M. NYAGWENCHA
Event: 2nd ECHO East Africa Pastoralist Symposium (2016-03-01)
Session: Water filtration methods including use of Biosand Filters and Hollow Fiber Membrane filters Aqua Clara's entrepreneurial approach to providing safe water for all communities Training for other organization's to replicate the BSF and HF filters for their organization. Aqua Clara International (ACI) has been working in Kenya since 2008. Through its program, over 3,000 households have gained access to safe drinking water. ACI works by training local people to make effective, affordable water, sanitation and hygiene (WASH) products emphasizing the importance of 'entrepreneurs' and LOCAL revenue generating products...at an affordable cost.
Biographical Information: John Nyagwencha has been working as the Operations Manager for a small Christian NGO called Aqua Clara International since 2011. As part of his work, he trains members of the community to manufacture and sell WASH products including Biosand filters and essentially build businesses that can supplement their income. He also oversees Community Health Promoters who carry out monitoring as well as WASH-related training in homes and schools. John is completing a Master of Science degree in Environmental Legislation and Management from Jomo Kenyatta University.